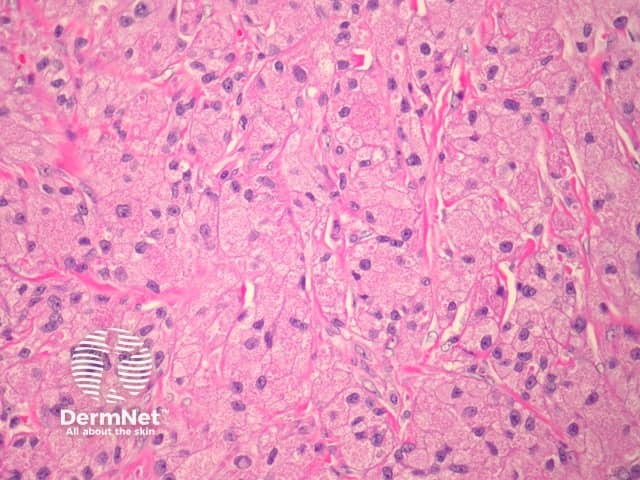
Figure 1

Main menu
Common skin conditions
NEWS
Join DermNet PRO
Read more
Quick links
Lesions (benign) Diagnosis and testing
Author: Assoc Prof Patrick Emanuel, Dermatopathologist, Auckland, New Zealand, 2013.
Introduction Histology Special studies Differential diagnoses
Granular cell tumour is also known as Abrikossoff tumour. It is thought to have a neural origin, probably derived from Schwann cells.
In granular cell tumour, sections show broad fascicles of tumour cells arranged in nests or sheets infiltrating the dermis and dermal structures. The tumour cells are large in size, with small, uniform, eosinophilic granules filling the cytoplasm, and small, round-to-oval nuclei (figures 1–3). Mitoses are rare.
'Pustulo-ovoid bodies of Milian' may be present (figure 2, arrow). These are large granules surrounded by a clear halo.
Sometimes, the overlying epidermis may become markedly hyperplastic and mimic a squamous cell carcinoma. This is thought to be a reactive phenomenon.
Malignant forms of granular cell tumour are extremely rare but reported. Frank anaplasia, increased mitotic activity and tumour necrosis are worrisome features.
Figure 1

Figure 2

Figure 3
S-100 protein is positive. PAS highlights granules after diastase digestion. Other positive stains may include neuron-specific enolase, CD68, CKI-C3.
Rhabdomyoma — These may be similar to granular cell tumour. Rhabdomyomas are positive with desmin and myoglobin.
Gingival granular cell tumour of newborn — These are morphologically similar to granular cell tumour but arise in a distinct clinical setting. S100 is negative.
Other tumours with granular cells – Granular cell change has been described in many other tumours (including dermatofibroma, fibrous papule, AFX and primitive polypoid granular cell tumour). S100 positivity is generally a useful diagnostic aid.